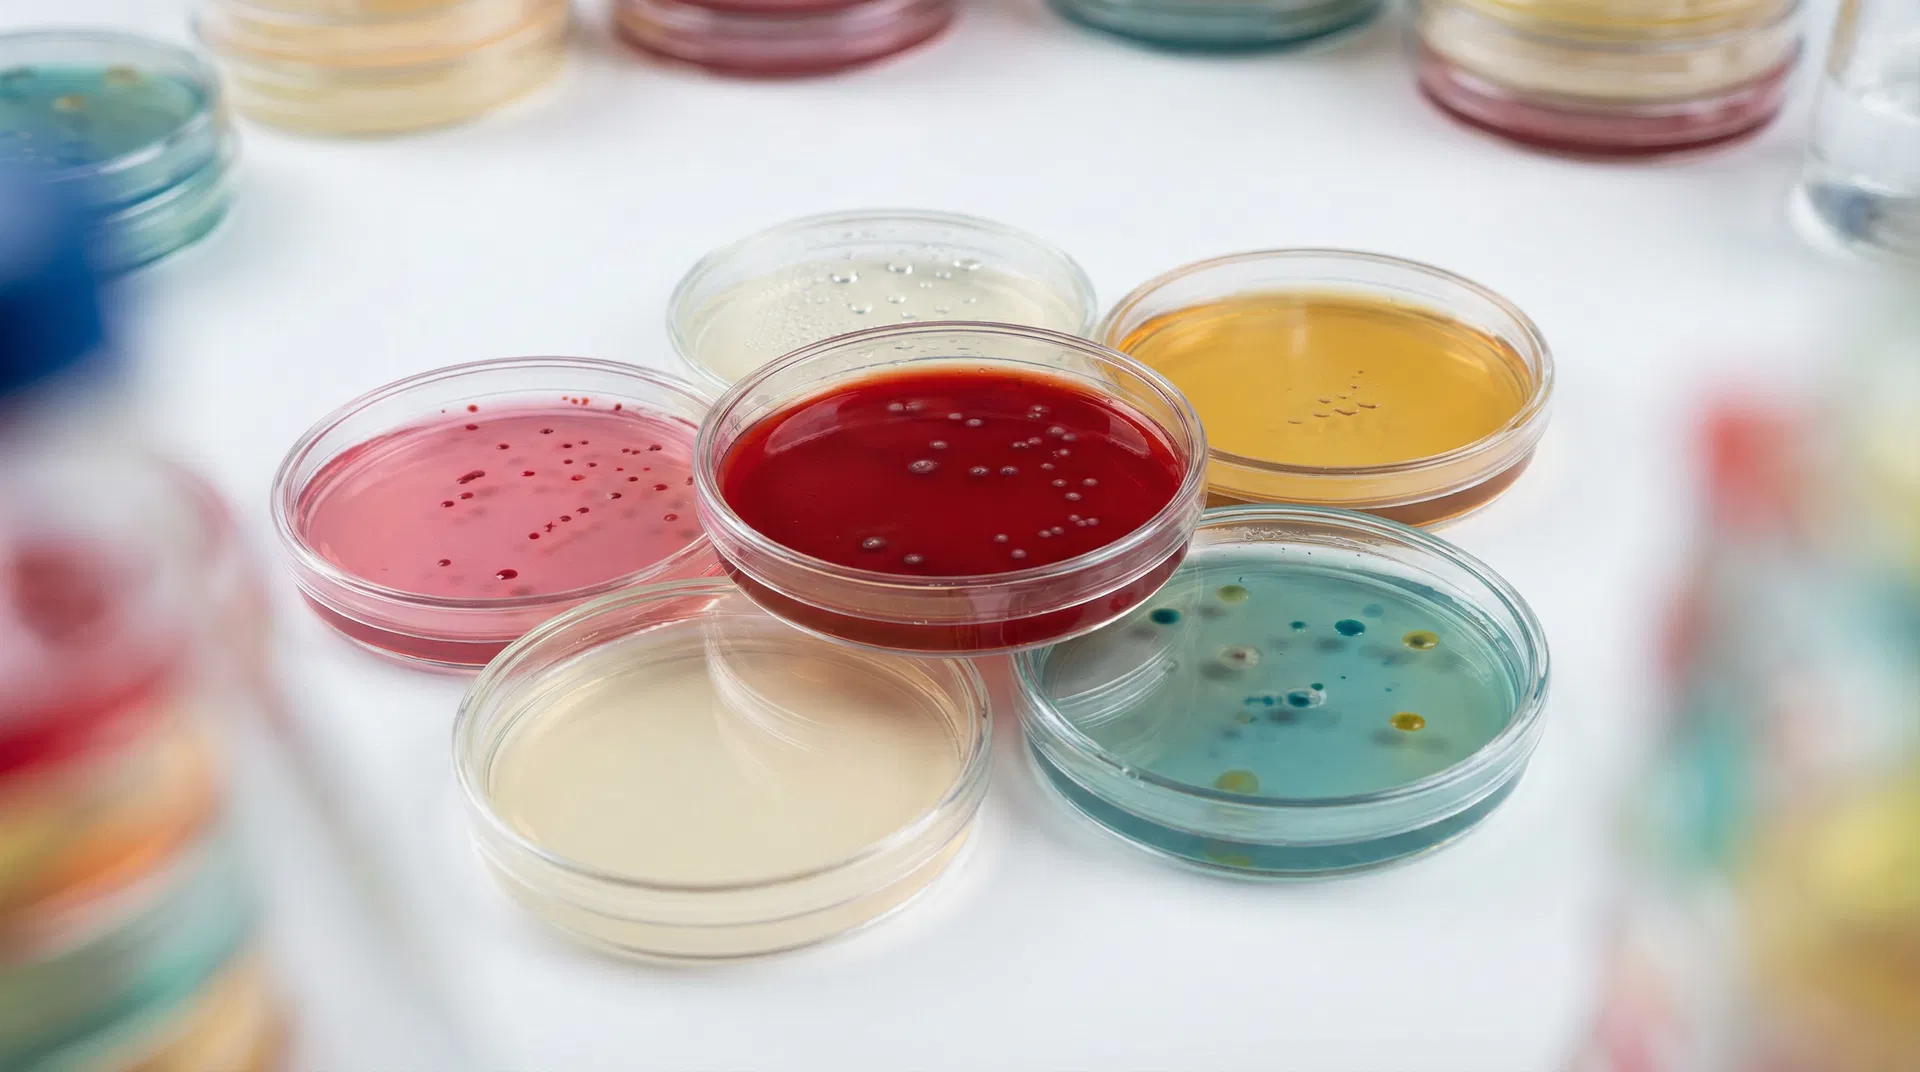

Media Types
Media Types
Browse our extensive catalog of over 390 microbiological culture media. Can't find what you need? Use the configurator to specify a custom medium.
Showing 391 of 391 results
A29
Acetamide Agar
Acetamide Broth
Acetamide Broth Base ISO
Acetamide Broth ISO
Acetate Differential Agar
Actinomycete Isolation Agar with Glycerol
Agar Base Aeromonas (RYAN)
Agar Test pH 6,0 for Inhibition Test
Agar Test pH 8,0 for Inhibition Test
Alicyclobacillus Detection Agar
Alkaline Peptone Water
Alkaline Peptone Water ISO
Amies Transport Medium without Charcoal
Amies Transport with Charcoal
Anaerobic Agar
Antibiotic Medium Nº 1 (Seed Agar) USP
Antibiotic Medium Nº 11 (Neomycin Test)
Antibiotic Medium Nº 12
Antibiotic Medium Nº 23
Antibiotic Medium Nº 5 (Streptomycin test) USP
Antibiotic Medium Nº 8 USP
Antibiotic Medium Nº10 EP
Antibiotic Medium Nº2 (Base Agar)
Antibiotic Medium Nº3 USP
APT Agar (All Purpose Tween)
APT Broth
Asparagine Broth
Azide Blood Agar Base
Azide Dextrose Broth
B42
Bacillus Cereus Selective Agar Base (MYP) ISO
Bacillus Cereus Selective Agar Base (PEMBA) ISO
Baird Parker Agar Base
BAT Broth
BCP Agar
BCP Glucose Agar
BCP Glucose Broth
Biggy Agar
Bile Esculin Agar ISO
Bile Esculin Azide Agar
Bile Esculin Azide Agar ISO
Bile Esculin Azide Broth
Bismuth Sulfite Agar (Wilson Blair) USP
Blood Agar Base
Blood Agar Base + Nalidixic Acid
Blood Agar Base Nº2 ISO
Bolton Selective Enrichment Broth Base ISO
Bordet-Gengou Agar Base
Bordet-Gengou Agar with Charcoal
BPRM Broth Base (Bacteroides Phage Recovery Medium)
Brain Heart Infusion Agar (BHI Agar)
Brain Heart Infusion Broth (BHI Broth)
Brain Heart Infusion Broth ISO
Brettanomyces Agar
Brettanomyces Selective Broth
Brilliant Green Agar
Brilliant Green Agar Modified ISO
Brilliant Green Agar with Sulfadiazine
Brilliant Green Bile Agar
Brilliant Green Bile Broth 2% ISO
Brilliant Green Tetrathionate Bile Broth
Brucella Agar
Brucella Broth
Brucella Medium Base
Bryant-Burkey Broth Base (modif. with resazurin)
Buffered Listeria Enrichment Broth with Supplements
Buffered Peptone Water EP/USP
Buffered Peptone Water ISO
Buffered Saline Peptone Water
Burkholderia Cepacia Agar Base
Burkholderia cepacia Selective Agar Base USP
Buti Medium
C21
Calcium Caseinate Agar
Campylobacter Agar Base (Preston)
Campylobacter Agar Base Blood Free (CCDA) ISO
Campylobacter Preston Broth Base ISO
Carbohydrates Utilization Broth Base ISO
Cary-Blair Medium
Cetrimide Agar Base EP/USP/ISO
Chapman Stone Agar
Chloramphenicol Agar (YGC Agar) ISO
CLED Agar (Cystine Lactose Electrolyte Deficient)
CLED Agar with Andrade´s Indicator
Clostridium Difficile Agar Base
Clostridium Perfringens Agar Base (m-CP)
Columbia Agar Base EP/USP/ISO
Columbia Broth
Columbia CNA Agar Base
Corn Meal Agar
Cronobacter Selective Broth (CSB) ISO
CTA Medium
Czapek-Dok Modified Broth
Czapek-Dox Modified Agar
D14
DCLS Agar (Desoxycholate, Citrate, Lactose, Sucrose)
Deoxycholate Citrate Agar
Dermatophytes Agar Base
Desoxycholate Agar
Desoxycholate Lactose Agar
DEV Lactose Broth
Dextrose Agar
Dextrose Broth (Glucose Broth)
Dextrose Tryptone Agar with Starch
Dey-Engley Neutralizing Broth ISO
Dichloran Glycerol Agar (DG 18) ISO
Differential Reinforced Clostridium Broth
DNAse Test Agar (Deoxyribonuclease Activity)
DNase Test Agar with Toluidine Blue (Deoxyribonuclease Activity)
E20
E. coli O157:H7 Presumptive ID Agar
EC Medium ISO
EC with MUG Fluorogenic Agar
EE Broth
Elliker Medium
Endo Agar Base
Endo Base Broth
Endo LES Agar Base
Enterococcus Confirmatory Agar
Enterococcus Selective Agar (Enterococcosel Agar)
Enterococcus Selective Broth (Emterococcosel Broth)
Eosin Methylene Blue Agar (EMB)
Esculin Iron Agar
ESTY Broth
ESTY Medium
Eugon Agar
Eugon LT 100 Agar
Eugon LT 100 Broth
EVA Broth (Ethyl, Violet, Azide, Litsky)
Ewing Malonate Broth Modified
F3
Fecal Coliforms Agar Base (m-FC)
Fecal Coliforms Broth Base (m-FC)
FMM Broth
G12
GC Agar Base
GC Broth
Gelatin Lactose Medium
Gelysate Agar (Plate Count Agar Sugar Free)
Giolitti-Cantoni Broth
Giolitti-Cantoni Broth ISO
Glucose Chloramphenicol Agar
Glucose Chloramphenicol Broth
Glucose OF Medium ISO
GN Enrichment Broth (Hajna)
Granada Agar Base
GYC Agar
H6
Haemophilus Test Medium
HC Agar Base
Heart Infusion Broth
Hektoen Enteric Agar ISO
Helicobacter Agar Modified
Hoyle Medium Base
I6
Indole Nitrite Medium (Trypticasein Nitrate Medium)
Inositol Brilliant Green Bile Agar (Plesiomonas Differential Agar)
Irgasan Ticarcillin and Potassium Chlorate Broth (ITC) ISO
Iron Agar (Lyngby)
Iron Sulfite Agar ISO
Iso-Sensitest Agar
K11
KAA Confirmatory Agar
KAA Presumptive Broth
KF Streptococcal Agar
KF Streptococcal Agar with Bromocresol Purple
KF Streptococcal Broth
King A Medium (Pseudomonas P) Agar USP/ISO
King B Medium (Pseudomonas F Agar) ISO
King FG Agar
Kliger Iron Agar
Kligler Iron Agar
Koser Citrate Broth
L32
Lactose Agar with Bromothymol Blue and Crystal Violet (Drigalski)
Lactose Broth
Lactose Broth with Bromocresol Purple
Lactose Glucuronide m-Agar (MLGA)
Lactose Peptone Broth DEV
Lactose Sulfite Broth Base ISO
Lauryl Sulfate Agar
Lauryl Sulfate Broth (Lauryl Tryptose Broth – LTB) ISO
Lauryl Sulphate Tryptose Broth Modified (mLST)
Legionella BCYE Agar Base ISO
Letheen Agar Modified
Letheen Broth Modified ISO/BAM
Levine Agar (EMB) ISO/BAM
LIM Medium (Lysine, Indole, Motility Medium)
Linden Grain Medium
Listeria Agar Base Oxford ISO
Listeria Agar Base Palcam ISO
Listeria Enrichment Broth Base ISO
Listeria Enrichment Broth With Supplements
Listeria Fraser Broth Base ISO
Listeria Half-Fraser Broth Base ISO
Liver Agar
Liver Broth
Liver Veal Agar
LMDA Agar
Loeffler Serum Medium Base
L-Ornithine Decarboxylation Medium ISO
Lowenstein Jensen Medium Base w/o M.Green
LPT Dilution Broth
Lysine Decarboxylase Broth
Lysine Decarboxylase Medium ISO
Lysine Iron Agar
M41
M17 Agar
Macconkey Agar EP/USP/ISO
MacConkey Agar Nº 2
MacConkey Agar w/o Crystal Violet and w/o Sodium Chloride
Macconkey Agar with Sorbitol (CT-SMAC) ISO
MacConkey Broth EP/USP
MAL Agar
Malonate Phenylalanine Broth
Malt Extract Agar
Malt Extract Broth
Mannitol Nitrate Motility Medium
Mannitol Salt Agar (MSA) (Chapman Medium) EP/USP/ISO
Mannitol Salt Broth
Marine Agar
Marine Broth
m-Dixon agar
M-Green Yeast and Mold Agar
Minerals Modified Glutamate Broth (MMBG) ISO
MIO Medium (Motility-Indole-Ornithine)
MLO Medium
Modified Nocive Brewers Bacteria Agar Base
Modified Salmonella Shigella Agar
Modified Scholten´s Broth
Modified Semisolid Rappaport Vassiliadis Medium (MSRV) ISO
Moeller KCN Broth Base
Mossel EE Broth EP/USP
Motility Test Medium
MRS Agar
MRS Agar Low pH ISO
MRS Broth
MRS Broth Low pH
MRS Broth w/o Dextrose
MRS Broth w/o Dextrose and w/o Beef Extract
MR-VP Medium
m-TEC Agar
Mueller Hinton Agar
Mueller Hinton Agar II
Mueller Hinton Broth
Muller Kauffmann Tetrathionate Broth Base
Muller Kaufmann Broth Base with brilliant Green and Novobiocin (MKTTN) ISO
Mycobiotic Agar (Fungal Selective Agar)
N10
Neutralizing Agar
Nitrate Broth
Nitrate Motility Base Medium
Nocive Brewers Bacteria Broth Base Modified
Nutrient Agar Dev Regulations
Nutrient Agar ISO
Nutrient Agar with Sodium Chloride ISO
Nutrient Broth
Nutrient Broth Nº2
Nutrient Gelatin
O4
Oatmeal Agar
OF Basal Medium (Hugh And Leifson)
OGA Medium (Oxytetracycline Glucose Agar Base) (OGYE)
Orange Serum Agar
P14
Peptone Water (Tryptone Water) ISO
Peptone Water with Lactose
Phenol Red Broth Base
Phenol Red Dextrose Agar
Phenol Red Dextrose Broth
Phenol Red Sucrose Broth
Phenylalanine Agar
Potato Dextrose Agar EP/USP
Potato Dextrose Broth
PPLO Agar Base w/o Crystal Violet
PPLO Broth Base w/o Crystal Violet
Presence-Absence Broth
Pseudomonas CFC Agar Base ISO
Pseudomonas CN Agar Base ISO
R14
R2A Agar EP/USP
R2A Agar w/o Agar
Raka-Ray Agar Base
Rappaport Soy Broth (Vassiliadis) ISO
Rappaport Vassiliadis Broth EP/USP
Reinforced Clostridal Agar
Reinforced Clostridial Medium EP/USP
Rogosa SL Agar
Rogosa SL Broth
Rose Bengal Agar + Chloramphenicol
Rose Bengal Agar + Cholamphenicol + Dichloran (DRBC Agar) ISO
Rosenow Broth
Rothe Agar (Glucose Agar w/ Azide)
Rothe Broth (Glucose Broth With Azide)
S43
Sabouraud Dextrose Agar + Chloramphenicol
Sabouraud Dextrose Agar + Chloramphenicol + Cycloheximide
Sabouraud Dextrose Agar + Chloramphenicol + Gentamicin
Sabouraud Dextrose Agar + Chloramphenicol EP/USP/ISO
Sabouraud Dextrose Agar + Cycloheximide
Sabouraud Dextrose Agar 2%
Sabouraud Dextrose Agar EP/USP/ISO
Sabouraud Dextrose Broth + Chloramphenicol
Sabouraud Dextrose Broth EP/USP
Sabouraud Fluid Medium
Saline Lactose Broth with Phenol Red
Saline Peptone Water ISO
Salmonella Shigella Agar (SS Agar)
Salmonella Shigella Agar with Sodium Deoxycholate and Calcium Chloride (SSDC)
Salmonella Shigella Broth
Salt Egg Yolk Agar Base
San Francisco Base Medium Modified
SCDLP 80 Broth ISO
Schaedler Agar
Schaedler Broth
Schubert Broth
Selenite Cystine Broth
Sellers Agar
Semisolid Nutrient Agar ISO
Shigella broth ISO
SIM Medium
Simmons Citrate Agar ISO
Slanetz-Bartley Medium ISO
Slanetz-Bartley Medium w/o TTC
Sodium Chloride Buffered Peptone Solution EP
Sodium Selenite Broth
Sorbitol Peptone Broth And Bile Salts (PSB) ISO
SPS Agar (Sulfite Polymyxin Sulfadiazine)
Standard Count Agar
Standard Methods Agar (PCA) ISO/APHA
Standard Methods Agar with Powdered Milk APHA/ISO
Standard Nutrient Agar I
Standard Nutrient Broth I
Staphyloccus Agar Nº 110
Streptococcus Selective Agar
Streptococcus Selective Agar Modified (without Neomycin without Colistin)
Stuart Transport Medium
Syncase Broth
T37
T.S.C. Agar Base (Tryptose Sulfite Cycloserine) ISO
TAT Broth Base (CPLP)
TCBS Agar ISO
Tetrathionate Broth Base 500 g
TGEA Medium (Tryptone Glucose Yeast Extract Agar)
Thioglycollate Broth NIH
Thioglycollate Fluid Medium EP/USP
Thioglycollate Fluid Medium without Indicator
Thioglycollate Medium ISO
Thrichomonas Broth (Kupferberg)
Todd Hewitt Broth
TOS Propionate Agar Base ISO
TPY Broth
Triple Sugar Iron Agar (TSI)
Triple Sugar Iron Agar (TSI) ISO
Trypticasein Glucose Extract Agar
Trypticasein Soy Agar (TSA) EP/USP/ISO
Trypticasein Soy Agar (TSA) Nº2
Trypticasein Soy Blood Agar Base
Trypticasein Soy Broth (TSB) EP/USP/ISO
Trypticasein Soy Broth (TSB) With Tween 80
Trypticasein Soy Broth Modified with Novobiocin (mTSB) ISO
Trypticasein Soy Broth w/o Dextrose
Tryptone Bile Salts Agar
Tryptophan Culture Broth ISO
Tryptose Agar
Tryptose Blood Agar Base
Tryptose Broth
Tryptose Phosphate Broth
Tryptose Phosphate Broth II
Tryptose Soy Agar ISO
TSA Agar Nº2 Modified
TSA Letheen Agar
TSN Agar (Tryptone Sulfite Neomycin)
TSYEA Agar (Tryptone Soy Yeast Extract Agar) ISO
TSYEB Broth (Tryptone Soy Yeast Extract Broth) ISO
TTC Chapman Agar (Lactose Agar TTC with Tergitol 7)
U6
Universal Beer Agar (UBA)
Urea Agar Base (Christensen) ISO
Urea Broth
Urea Indole Broth ISO
UVM-I Listeria Selective Enrichment Broth Modified
UVM-II Listeria Selective Enrichment Broth Modified
V8
Vancomycin Screen Agar
Vegetable Peptone Broth (TSB Vegetable)
Violet Red Bile Agar With Glucose (VRBG) EP/USP/ISO
Violet Red Bile Agar With Glucose and Lactose (VRBLG) USP
Violet Red Bile Agar With Lactose (VRBL) ISO
VL Anaerobic Blood Agar
Vogel-Johnson Agar
VP Semisolid Medium
W7
Wilkins Chalgren Medium
Wilkins Chalgren Medium II
WL Differential Agar
WL Nutrient Agar
WL Nutrient Broth
Wort Agar
Wort Broth
X3
XLD Agar (Xylose Lysine Desoxycholate Agar) EP/USP
XLD Agar (Xylose Lysine Desoxycholate Agar) ISO
XLT4 Agar Base
Y8
Yeast Extract Agar (YEA) ISO
Yeast Extract Agar for Molds
Yeast Extract Soy Agar
Yeast Extract Soy Broth (TSB no animal)
Yeast Mold Agar
Yeast Mold Broth
Yersinia Selective Agar Base (CIN) ISO
YSG Broth
Can't find your medium?
Use our configurator to specify a custom medium that's not in our standard catalog.
Configure Media